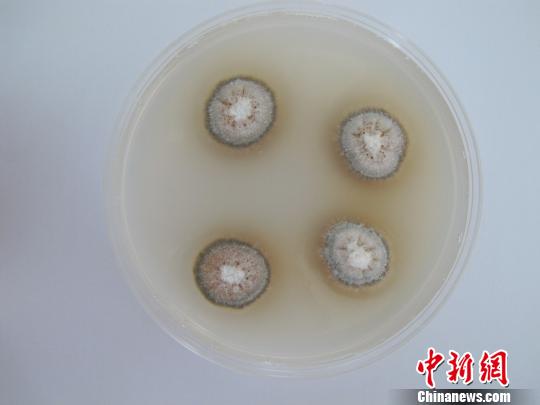
浙江口岸首次截获苹果牛眼果腐病菌 堪称 苹果

苹果牛是网络游戏魔兽世界中国区的全能型传奇人物,其视频Gforce2更是将国服视频推向了一个新的时代,并且
战神”苹果牛在游戏里是瘦削的亡灵战士,依靠精湛的技术杀人如麻。在全世界游戏玩家圈子中,他都是响当当的
苹果牛是网络游戏魔兽世界中国区的全能型传奇人物,其视频Gforce2更是将国服视频推向了一个新的时代,并且
苹果牛,男,网络游戏魔兽世界中国区的传奇人物。其视频Gforce2将国服视频推向了一个新的时代,并且在国外
Hi,这是 苹果牛 的腾讯微博,立即登录并收听,新鲜动态尽收眼底!承接各种游戏宣传片、微电影等制作~
有问题,上知乎。知乎是中文互联网知名知识分享平台,以「知识连接一切」为愿景,致力于构建一个人人都可以
苹果牛 天堂在左,战士向右 天堂在左,战士向右 1673 视频 96 栏目 9 播放量 8.0万 微信分享
2011年全球最佳PVP玩家人物出炉,国服战士玩家苹果牛排名第四。

魔兽红人苹果牛回忆和魔兽的第一次
333x500 - 33KB - JPEG

wow苹果牛将助阵wmg3
472x422 - 67KB - JPEG

魔兽红人苹果牛回忆和魔兽的第一次
550x309 - 33KB - JPEG

亡灵战士PVP视频 Gforce3预告片 苹果牛
500x667 - 46KB - JPEG

风暴战区 正式邀请中国最有影响力玩家精英评
500x375 - 21KB - JPEG

魔兽名人苹果牛:九阴真经生活技能够新颖丰富
690x388 - 67KB - JPEG

魔兽名人苹果牛:九阴真经生活技能够新颖丰富
690x388 - 48KB - JPEG

苹果牛眼烂果病
300x225 - 11KB - JPEG

苹果牛:V大将现身Gforce视频,玩战士要淡定
300x240 - 19KB - JPEG

全球十佳PVP玩家排名及视频集:苹果牛排名第
499x325 - 46KB - JPEG

天堂在左,战士向右-Gforce2 苹果牛PVP视频
331x210 - 13KB - JPEG

【图】苹果牛仔裤+苹果牌男士牛仔裤
710x713 - 126KB - JPEG
浙江口岸首次截获苹果牛眼果腐病菌 堪称 苹果
540x405 - 14KB - JPEG

苹果牛就用这个 网销热门游戏耳机推荐
500x439 - 58KB - JPEG

Gforce 5 - 无所畏惧_17173游戏视频
152x122 - 5KB - JPEG